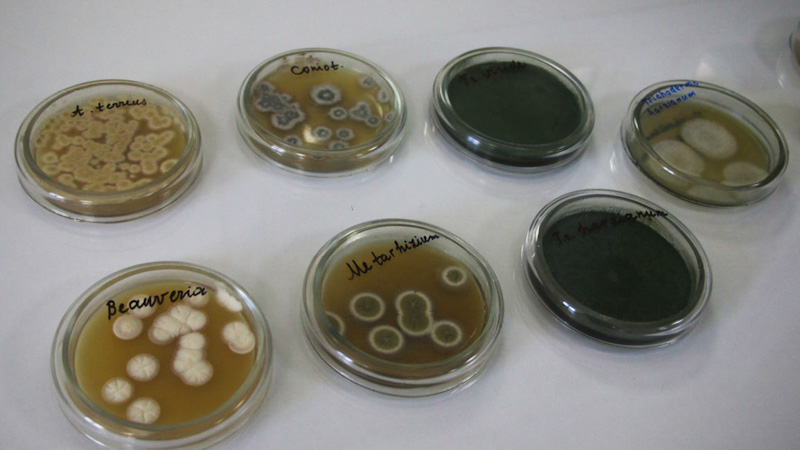

А не так давно тут вирішили розширити своє виробництво, збудувавши нову потужну лінію. Для ознайомлення зі своїми планами та з процесом створення препаратів компанія запросила до себе аграрних журналістів.
Нині БТУ-ЦЕНТР — це виробництво повного циклу зі своїми виробничими потужностями, лабораторіями та складськими приміщеннями. На підприємстві розробляють комплексні біологічні рішення для агровиробників — від відбирання найактивніших штамів мікроорганізмів для напрацювання препаратів до постачання готового продукту й індивідуальних консультацій із біологізації технологій землеробства.
«У 2019 році ми стали єдиною українською компанією, яку визнала Міжнародна асоціація виробників засобів біоконтролю (International Biocontrol Manufacturers Association, Швейцарія). Це є безумовним свідченням ефективності нашої роботи», — сказав під час престуру Владислав Болоховський, директор групи компаній БТУ-ЦЕНТР.
Біопрепарати в Україні та світі
За даними незалежної аналітичної компанії Pro Consulting, із 5% біопрепаратів, які застосовують на українських землях, імпорт становить 40%. Решта ж — препарати вітчизняного виробництва, що передусім стосується інокулянтів. Частка БТУ-ЦЕНТР на ринку біопрепаратів України становить 27,9%. Нині фірма продукує 57 біопрепаратів для сільського господарства, з яких 54 — препарати, сертифіковані «Органік Стандарт» для органічного землеробства.
Крім того, за даними тієї самої Pro Consulting, БТУ-ЦЕНТР уже кілька років поспіль є найбільшим експортером мікробіологічних препаратів в Україні й постачає свою продукцію в
15 країн світу. До того ж у більше ніж в 10 країнах проводять дослідження їх ефективності.
За словами Владислава Болоховського, в Україні препаратами БТУ-ЦЕНТР обробляють близько 3 млн гектарів, а потужність виробництва — 10 тис. тонн препаратів на рік виводить компанію в лідери виробництва мікробіологічних препаратів.

Біологізацію — великим полям
Однак не слід думати, що мікробні препарати застосовують тільки ті господарства, що ведуть органічне землеробство. Продукти компанії активно застосовують також і в агрохолдингах — «Кернел», «МХП», «Укрлендфармінг», «Епіцентр К» і багато інших. Якщо 80% біопрепаратів у світі купують для овочів і фруктів, то за досвідом ладижинських мікробіологів в Україні понад 90% продажу відбувається для виробництва польових культур.
«З нами співпрацює практично половина агрохолдингів України, — розповіла комерційна директорка компанії Тетяна Хоменко. — І це стосується не тільки забезпечення препаратами. Спільними зусиллями ми проводимо наукову роботу й дослідження».
Ось, до прикладу, «Кернел» уже багато років тому став на шлях біологізації свого виробництва. Щодо технологій БТУ-ЦЕНТР, цей агрохолдинг застосовує технологію Біодеструктора стерні. Водночас компанія постійно звертається до фахівців із Ладижина з пропозиціями щодо створення нових продуктів.
«Сам агрохолдинг має доволі потужний науково-дослідний центр, на базі якого ми проводимо спільні дослідження практично по кожній культурі, — прокоментувала Тетяна Хоменко. — Це стосується і мобілізаторів фосфору та калію, і мікоризних продуктів. Сьогодні ми також підбираємо спеціальні комбінації препаратів для тих технологій, що застосовують на полях агрохолдингу».
Іншим цікавим прикладом є «Укрлендфармінг», який активно застосовує на своїх полях прилипач природного походження Липосам®, що використовують у бакових сумішах із засобами захисту рослин, а також Липосам® біоклей для запобігання розтріскування стручків ріпаку. Окрім того, агрохолдинг користується й інокулянтами ладижинського виробництва.

Наука — це фундамент
За роки роботи в компанії нагромаджено колосальні знання і практичний досвід у сфері виробництва агропродукції. Основоположне значення тут має наука. А тому фундаментом створення біопрепаратів у БТУ-ЦЕНТР по праву є Музей штамів, де зберігається понад 200 активних штамів мікроорганізмів, виділених із природних джерел — ґрунту, рослин тощо.
«Музей штамів — це своєрідний фундамент нашого виробництва» — розповіла головний мікробіолог БТУ-ЦЕНТР, лауреат Державної премії в галузі науки й техніки Ольга Нагорна. — Ми використовуємо найактивніші штами, виділені з природних джерел, і тільки ті, у яких доведена нешкідливість. За результатами найкращої ефективності депонуємо їх у Державному депозитарії України та зберігаємо у власному музеї».
Якісною особливістю, що відрізняє компанію від інших виробників біопрепаратів, є наявність власного науково-дослідного центру — Інституту прикладної біотехнології.
«Завдання Інституту — не тільки аналізувати агрохімічні показники проб ґрунту, — розповів Володимир Круть, старший мікробіолог Інституту. — Науковці також проводять фітопатологічну й ентомологічну експертизу для партнерів компанії, провадять власну і партнерську розробку унікальних форм препаратів».
Наприклад, саме в лабораторіях Інституту прикладної біотехнології та виробничих лабораторіях БТУ-ЦЕНТР народився біофунгіцид проти білої гнилі Склероцид®.
Виробничі потужності для забезпечення якості
Звичайно, де буває підприємство без виробничих потужностей? А тому журналістів провели по лініях виробництва мікробіологічних препаратів — як наявним, так і новим.
Зрозуміло, що процес отримання того чи іншого продукту є складним і високотехнологічним. Для забезпечення якості на виробничих лініях БТУ-ЦЕНТР працюють багатоступеневі системи очищення повітря та води, системи підготовки поживного середовища й контролю температур. Що цікаво: усі виробничі лінії розроблено за власними інженерними проєктами компанії. А усі вузли цих ліній виготовлено, за словами Володимира Крутя, в Україні з українських матеріалів. Отже, українська якість справді існує. Цього року тут збираються запустити ще одну лінію з виробництва біопрепаратів — ще більшу, і ще потужнішу. Щодо готової продукції, то вся вона чекає на відправлення кінцевому споживачеві в спеціальних складських приміщеннях, у яких суворо дотримуються контролю температури.

Вихід на новий рівень
Плани БТУ-ЦЕНТР масштабні. Невдовзі на заводі буде побудовано лінійку для виробництва препаратів для медицини — пробіотиків. Разом із цим для поширення продукції на міжнародні ринки в компанії вирішили зареєструвати представництво в Німеччині, через яке європейських споживачів інформуватимуть про український бренд та українські досягнення у сфері біотехнологій.
ТМ «Жива Земля» для фірми — це не просто гучна назва торгової марки, це образ мислення, філософія, яку сповідує весь колектив БТУ-ЦЕНТР. Біологізація землеробства та зменшення використання хімічних засобів захисту рослин — ось що є рушієм до дій цього виробника. І ці ідеї ладижинські мікробіологи готові обстоювати як в Україні, так і на міжнародному рівні.
Ростислав ПАНІЧЕВ, спеціально для Агробізнесу Сьогодні





